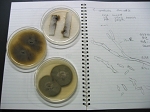

日時: 2002年9月24日(火)-26日(木)
場所: 筑波大学 菅平高原実験センター (長野県)
講師: 岡田 元 先生 (理化学研究所)
平成14年度日本菌学会関東支部第16回菌学ワークショップ「Cladosporiumおよび関連属菌の分類(入門編)」は、ワークショップ担当幹事(岡田)自らが講師を務め、9月24日~26日に筑波大学菅平高原実験センターにおいて開催されました。関東・甲信越・東海・近畿地方の大学や研究所などより研究者や学生、33名が参加いたしました。Cladosporium属の代表種や同定が容易と思われる種、ならびにFulvia fulva などの類似菌類について、できる限り確実な (authentic) 培養菌株と標本を用いて、既知の邦文や未発表データも併用し、平易に解説しました。難解な菌群ですが、入門編のワークショップとして参加者の皆さんに多少なりとも満足していただけたのであれば、企画者ならびに講師として幸いです。
さて、Cladosporium属の分類学的再検討の早急な実施については、今から15年以上も前にHawksworth (1986) により求められました。その後、菌類分子系統学が台頭し、遺伝子塩基配列を決定する技術もごく一般的なものとして定着してきました。しかし、現在もなお誰もが感じているように、Cladosporiumおよび関連属菌の分類は依然として混沌とした状況から抜け出せません。解析技術が進歩しても、解析に利用されるしっかりとした材料を容易に入手できるシステムが確立していないことが主因と思われます。言い換えれば、新分類群の発表の際や、既知種であっても重要と思われる菌類を研究した際に、証拠や将来の研究材料となる標本と菌株のセットをしかるべき保存機関に保存してこなかった研究者や保存機関関係者の人為的な問題ではないでしょうか。Cladosporium属に限ったことではありませんが、このようなバウチャーの保存・供給制度の確立と運用が適正になされなければ、菌類分類学の将来はないような気がしてなりません。
今後も、実用的かつ魅力的な菌学ワークショップを分類同定に携わる方々のために開催し、菌類の系統学や分類学の火を絶やさないように、皆様と協力しながら努力するつもりです。どうかこれからも宜しくお願い申し上げます。
平成14年10月
岡田 元 (ワークショップ担当幹事)